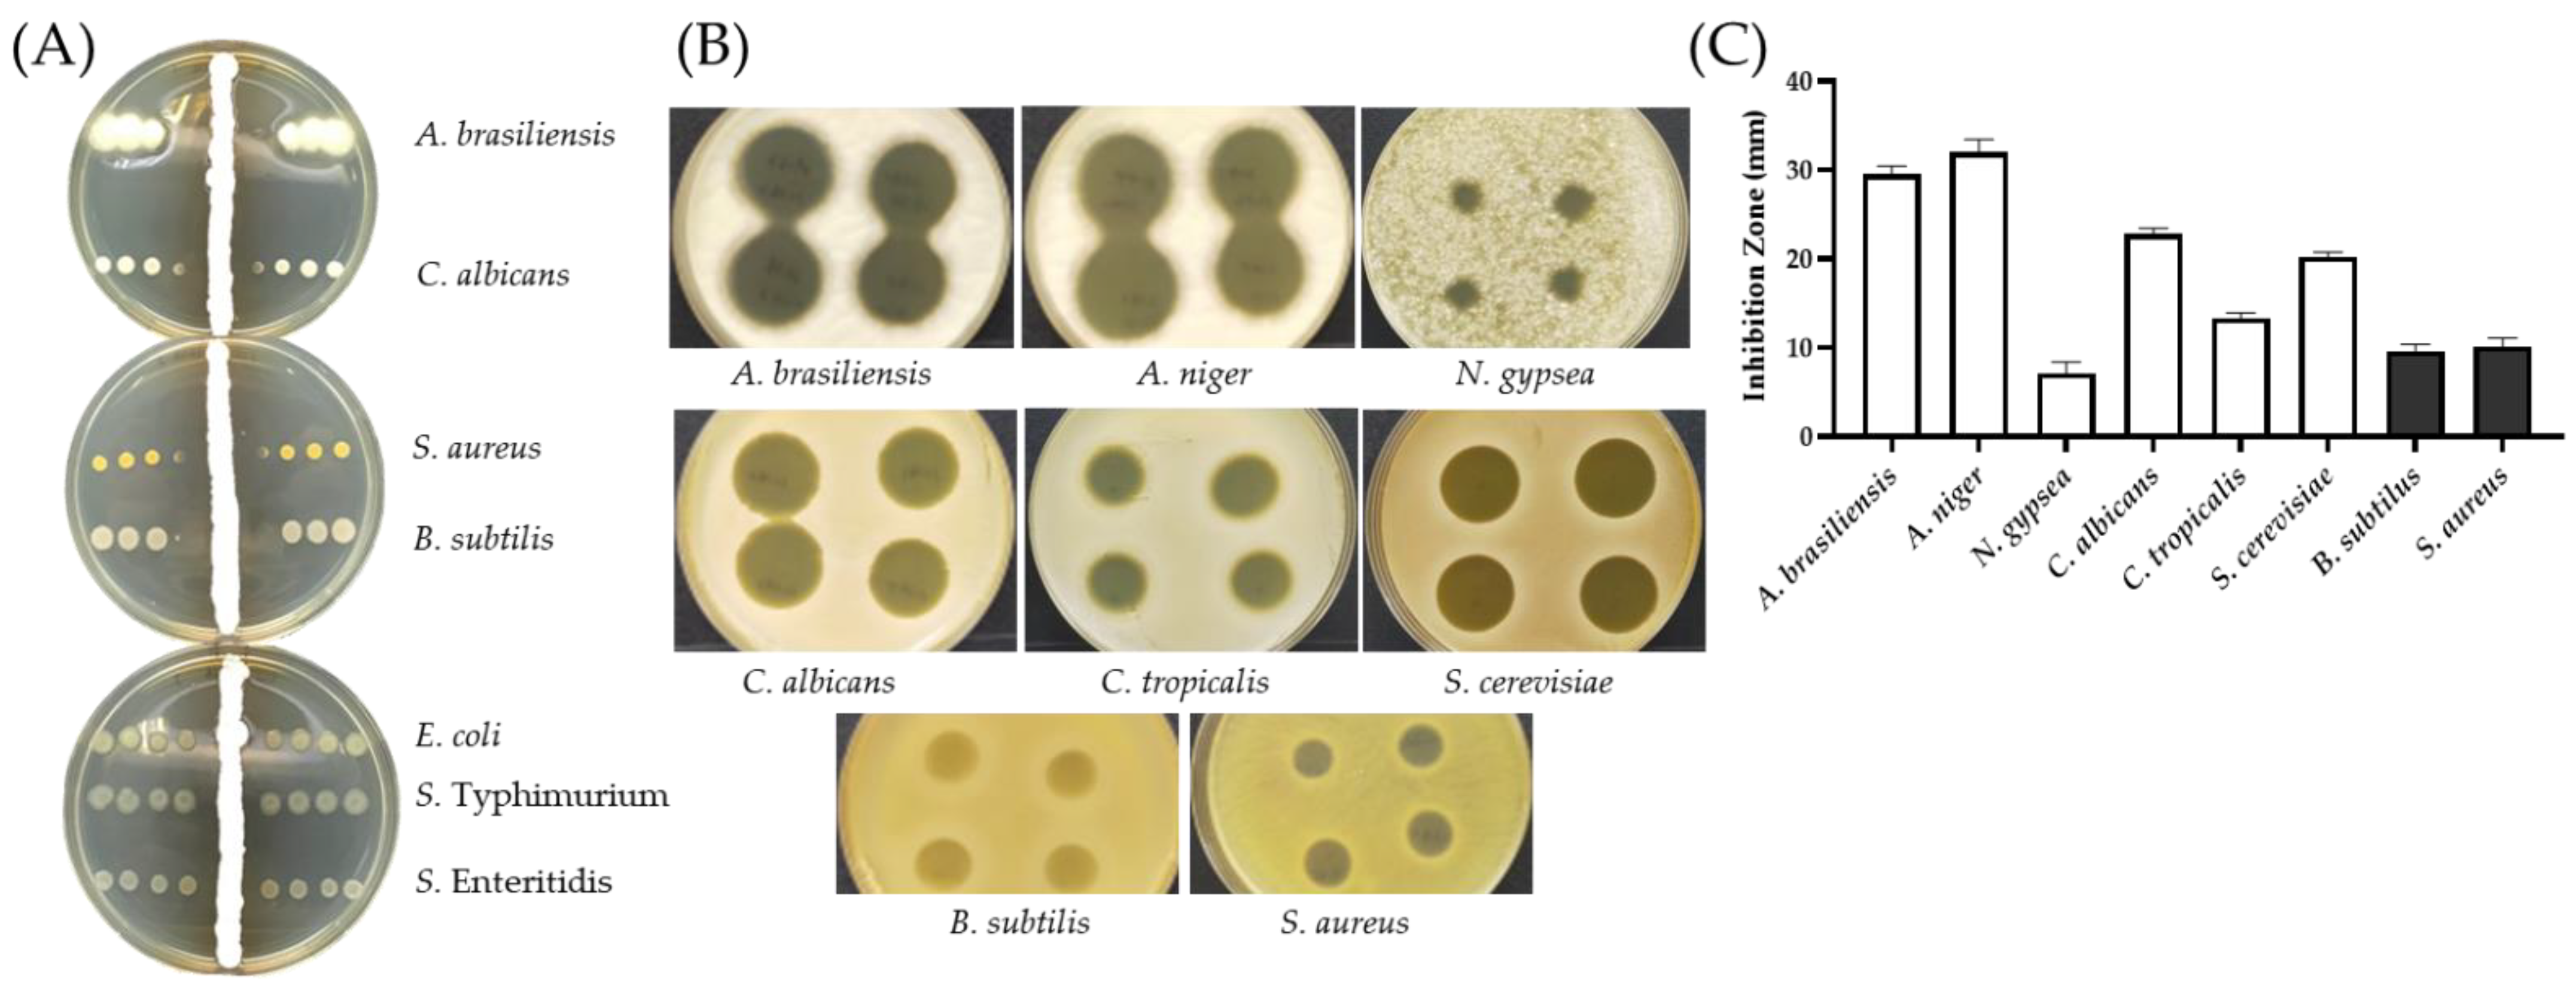

A Soil-Isolated Streptomyces spororaveus Species Produces a High-Molecular-Weight Antibiotic AF1 against Fungi and Gram-Positive Bacteria
Abstract
1. Introduction
2. Results and Discussion
2.1. Isolation of Antibiotic-Producing SC26
2.2. Isolation and Characterization of UV-Mutagenesis Derivatives
2.3. Antimicrobial Activities of AF1 from SC263
2.4. Characterization of the SC263 Antibiotics by Membrane-Filtration
2.5. Genomic Sequence of SC263
2.6. Biosynthetic Gene Clusters in SC263
3. Materials and Methods
3.1. Soil Sample Collection and Isolation of SC26
3.2. Morphology under Electron Microscope
3.3. Phylogenetic Analysis of 16S rRNA
3.4. Microbial Strains and Culture Conditions
3.5. Cross Streak Screening for Antibiotic Activity
3.6. Zone of Inhibition Assays for Antibiotic Activities
3.7. Membrane-Filtration Concentration of SC263
3.8. UV Mutagenesis of SC26
3.9. Treatment with Lytic Enzymes
3.10. Genomic DNA Purification
3.11. Whole-Genome Sequencing
3.12. Genomic Analysis
4. Conclusions
Supplementary Materials
Author Contributions
Funding
Institutional Review Board Statement
Informed Consent Statement
Data Availability Statement
Acknowledgments
Conflicts of Interest
References
- Toner, E.; Adalja, A.; Gronvall, G.K.; Cicero, A.; Inglesby, T.V. Antimicrobial resistance is a global health emergency. Health Secur. 2015, 13, 153–155. [Google Scholar] [CrossRef] [PubMed]
- Nature, E. The antibiotic alarm. Nature 2013, 495, 141. [Google Scholar] [CrossRef]
- Bartlett, J.G.; Gilbert, D.N.; Spellberg, B. Seven ways to preserve the miracle of antibiotics. Clin. Infect. Dis. 2013, 56, 1445–1450. [Google Scholar] [CrossRef]
- Michael, C.A.; Dominey-Howes, D.; Labbate, M. The antimicrobial resistance crisis: Causes, consequences, and management. Front. Public Health 2014, 2, 145. [Google Scholar] [CrossRef]
- Gross, M. Antibiotics in crisis. Curr. Biol. 2013, 23, R1063–R1065. [Google Scholar] [CrossRef] [PubMed]
- World Health Organization. Global Action Plan on Antimicrobial Resistance; World Health Organization: Geneva, Switzerland, 2015.
- Ventola, C.L. The antibiotic resistance crisis: Part 1: Causes and threats. Pharm. Ther. 2015, 40, 277–283. [Google Scholar]
- Whaley, S.G.; Berkow, E.L.; Rybak, J.M.; Nishimoto, A.T.; Barker, K.S.; Rogers, P.D. Azole Antifungal Resistance in Candida albicans and Emerging Non-albicans Candida Species. Front. Microbiol. 2017, 7, 2173. [Google Scholar] [CrossRef]
- Zhang, L.; Xiao, M.; Watts, M.R.; Wang, H.; Fan, X.; Kong, F.; Xu, Y.-C. Development of fluconazole resistance in a series of Candida parapsilosis isolates from a persistent candidemia patient with prolonged antifungal therapy. BMC Infect. Dis. 2015, 15, 340. [Google Scholar] [CrossRef]
- Healey, K.R.; Zhao, Y.; Perez, W.B.; Lockhart, S.R.; Sobel, J.D.; Farmakiotis, D.; Kontoyiannis, D.P.; Sanglard, D.; Taj-Aldeen, S.J.; Alexander, B.D.; et al. Prevalent mutator genotype identified in fungal pathogen Candida glabrata promotes multi-drug resistance. Nat. Commun. 2016, 7, 11128. [Google Scholar] [CrossRef]
- Segal, B.H.; DeCarlo, E.S.; Kwon-Chung, K.J.; Malech, H.L.; Gallin, J.I.; Holland, S.M. Aspergillus nidulans infection in chronic granulomatous disease. Medicine 1998, 77, 345–354. [Google Scholar] [CrossRef]
- McKeny, P.T.; Nessel, T.A.; Zito, P.M. Antifungal Antibiotics. In StatPearls [Internet]; StatPearls Publishing: St. Petersburg, FL, USA, 2021. [Google Scholar]
- Ostrosky-Zeichner, L.; Rex, J.H.; Pappas, P.G.; Hamill, R.J.; Larsen, R.A.; Horowitz, H.W.; Powderly, W.G.; Hyslop, N.; Kauffman, C.A.; Cleary, J.; et al. Antifungal susceptibility survey of 2,000 bloodstream Candida isolates in the United States. Antimicrob. Agents Chemother. 2003, 47, 3149–3154. [Google Scholar] [CrossRef] [PubMed]
- Mehrad, B.; Paciocco, G.; Martinez, F.J.; Ojo, T.C.; Iannettoni, M.D.; Lynch, J.P., 3rd. Spectrum of Aspergillus infection in lung transplant recipients: Case series and review of the literature. Chest 2001, 119, 169–175. [Google Scholar] [CrossRef] [PubMed]
- Eriksson, U.; Seifert, B.; Schaffner, A. Comparison of effects of amphotericin B deoxycholate infused over 4 or 24 hours: Randomised controlled trial. BMJ 2001, 322, 579–582. [Google Scholar] [CrossRef] [PubMed][Green Version]
- Patil, A.; Lakhani, P.; Majumdar, S. Current perspectives on natamycin in ocular fungal infections. J. Drug Deliv. Sci. Technol. 2017, 41, 206–212. [Google Scholar] [CrossRef]
- Chassagne, F.; Cabanac, G.; Hubert, G.; David, B.; Marti, G. The landscape of natural product diversity and their pharmacological relevance from a focus on the Dictionary of Natural Products®. Phytochem. Rev. 2019, 18, 601–622. [Google Scholar] [CrossRef]
- Hutchings, M.I.; Truman, A.W.; Wilkinson, B. Antibiotics: Past, present and future. Curr. Opin. Microbiol. 2019, 51, 72–80. [Google Scholar] [CrossRef]
- De Lima Procópio, R.E.; da Silva, I.R.; Martins, M.K.; de Azevedo, J.L.; de Araújo, J.M. Antibiotics produced by Streptomyces. Braz. J. Infect. Dis. 2012, 16, 466–471. [Google Scholar] [CrossRef]
- Watve, M.G.; Tickoo, R.; Jog, M.M.; Bhole, B.D. How many antibiotics are produced by the genus Streptomyces? Arch Microbiol. 2001, 176, 386–390. [Google Scholar] [CrossRef]
- Nicault, M.; Tidjani, A.-R.; Gauthier, A.; Dumarcay, S.; Gelhaye, E.; Bontemps, C.; Leblond, P. Mining the Biosynthetic Potential for Specialized Metabolism of a Streptomyces Soil Community. Antibiotics 2020, 9, 271. [Google Scholar] [CrossRef]
- Eom, S.H.; Kim, Y.M.; Kim, S.K. Marine bacteria: Potential sources for compounds to overcome antibiotic resistance. Appl. Microbiol. Biotechnol. 2013, 97, 4763–4773. [Google Scholar] [CrossRef]
- Awad, H.; El–Shahed, K.; Aziz, R.; Sarmidi, M.; El Enshasy, H. Antibiotics as Microbial Secondary Metabolites: Production and Application. J. Tekologi 2012, 59, 101–111. [Google Scholar] [CrossRef]
- Garrigues, S.; Gandía, M.; Castillo, L.; Coca, M.; Marx, F.; Marcos, J.F.; Manzanares, P. Three Antifungal Proteins From Penicillium expansum: Different Patterns of Production and Antifungal Activity. Front. Microbiol. 2018, 9, 2370. [Google Scholar] [CrossRef] [PubMed]
- Selitrennikoff, C.P. Antifungal proteins. Appl. Environ. Microbiol. 2001, 67, 2883–2894. [Google Scholar] [CrossRef]
- Messer, W. The bacterial replication initiator DnaA. DnaA and oriC, the bacterial mode to initiate DNA replication. FEMS Microbiol. Rev. 2002, 26, 355–374. [Google Scholar] [CrossRef] [PubMed]
- Jakimowicz, D.; Majka, J.; Messer, W.; Speck, C.; Fernandez, M.; Cruz Martin, M.; Sanchez, J.; Schauwecker, F.; Keller, U.; Schrempf, H.; et al. Structural elements of the Streptomyces oriC region and their interactions with the DnaA protein. Microbiology 1998, 144 Pt 5, 1281–1290. [Google Scholar] [CrossRef] [PubMed]
- Rajewska, M.; Wegrzyn, K.; Konieczny, I. AT-rich region and repeated sequences—The essential elements of replication origins of bacterial replicons. FEMS Microbiol. Rev. 2012, 36, 408–434. [Google Scholar] [CrossRef] [PubMed]
- Yoon, S.H.; Ha, S.M.; Lim, J.; Kwon, S.; Chun, J. A large-scale evaluation of algorithms to calculate average nucleotide identity. Antonie Van Leeuwenhoek 2017, 110, 1281–1286. [Google Scholar] [CrossRef] [PubMed]
- Blin, K.; Shaw, S.; Kloosterman, A.M.; Charlop-Powers, Z.; van Wezel, G.P.; Medema, M.H.; Weber, T. antiSMASH 6.0: Improving cluster detection and comparison capabilities. Nucleic Acids Res. 2021, 49, W29–W35. [Google Scholar] [CrossRef]
- Al-Askar, A.; Rashad, Y. In vitro antifungal activity of Streptomyces spororaveus RDS28 against some phytopathogenic fungi. Afr. J. Agric. Res. 2011, 6, 2835–2842. [Google Scholar]
- Frank, J.A.; Reich, C.I.; Sharma, S.; Weisbaum, J.S.; Wilson, B.A.; Olsen, G.J. Critical evaluation of two primers commonly used for amplification of bacterial 16S rRNA genes. Appl. Environ. Microbiol. 2008, 74, 2461–2470. [Google Scholar] [CrossRef]
- Boratyn, G.M.; Thierry-Mieg, J.; Thierry-Mieg, D.; Busby, B.; Madden, T.L. Magic-BLAST, an accurate RNA-seq aligner for long and short reads. BMC Bioinform. 2019, 20, 405. [Google Scholar] [CrossRef] [PubMed]
- Tamura, K.; Stecher, G.; Kumar, S. MEGA11: Molecular Evolutionary Genetics Analysis Version 11. Mol. Biol. Evol. 2021, 38, 3022–3027. [Google Scholar] [CrossRef] [PubMed]
- Edgar, R.C. MUSCLE: Multiple sequence alignment with high accuracy and high throughput. Nucleic Acids Res. 2004, 32, 1792–1797. [Google Scholar] [CrossRef] [PubMed]
- Kumar, P.S.; Raj, J.P.; Duraipandiyan, V.; Ignacimuthu, S. Antibacterial activity of some actinomycetes from Tamil Nadu, India. Asian Pac. J. Trop. Biomed. 2012, 2, 936–943. [Google Scholar] [CrossRef]
- Bhargav, H.S.; Shastri, S.D.; Poornav, S.P.; Darshan, K.M.; Nayak, M.M. Measurement of the Zone of Inhibition of an Antibiotic. In Proceedings of the 2016 IEEE 6th International Conference on Advanced Computing (IACC), Bhimavaram, India, 27–28 February 2016; pp. 409–414. [Google Scholar]
- Kumar, A.K. UV mutagenesis treatment for improved production of endoglucanase and β-glucosidase from newly isolated thermotolerant actinomycetes, Streptomyces griseoaurantiacus. Bioresour. Bioprocess. 2015, 2, 22. [Google Scholar] [CrossRef]
- Kutchma, A.J.; Roberts, M.A.; Knaebel, D.B.; Crawford, D.L. Small-scale isolation of genomic DNA from Streptomyces mycelia or spores. Biotechniques 1998, 24, 452–456. [Google Scholar] [CrossRef]
- Sullivan, M.J.; Petty, N.K.; Beatson, S.A. Easyfig: A genome comparison visualizer. Bioinformatics 2011, 27, 1009–1010. [Google Scholar] [CrossRef]
- Bos, J.D.; Meinardi, M.M. The 500 Dalton rule for the skin penetration of chemical compounds and drugs. Exp. Dermatol. 2000, 9, 165–169. [Google Scholar] [CrossRef]

Publisher’s Note: MDPI stays neutral with regard to jurisdictional claims in published maps and institutional affiliations. |
© 2022 by the authors. Licensee MDPI, Basel, Switzerland. This article is an open access article distributed under the terms and conditions of the Creative Commons Attribution (CC BY) license (https://creativecommons.org/licenses/by/4.0/).
Share and Cite
Chang, P.-C.; Liu, S.-C.; Ho, M.-C.; Huang, T.-W.; Huang, C.-H. A Soil-Isolated Streptomyces spororaveus Species Produces a High-Molecular-Weight Antibiotic AF1 against Fungi and Gram-Positive Bacteria. Antibiotics 2022, 11, 679. https://doi.org/10.3390/antibiotics11050679
Chang P-C, Liu S-C, Ho M-C, Huang T-W, Huang C-H. A Soil-Isolated Streptomyces spororaveus Species Produces a High-Molecular-Weight Antibiotic AF1 against Fungi and Gram-Positive Bacteria. Antibiotics. 2022; 11(5):679. https://doi.org/10.3390/antibiotics11050679
Chicago/Turabian StyleChang, Pu-Chieh, Shao-Chung Liu, Ming-Chun Ho, Tzu-Wen Huang, and Chih-Hung Huang. 2022. "A Soil-Isolated Streptomyces spororaveus Species Produces a High-Molecular-Weight Antibiotic AF1 against Fungi and Gram-Positive Bacteria" Antibiotics 11, no. 5: 679. https://doi.org/10.3390/antibiotics11050679
APA StyleChang, P.-C., Liu, S.-C., Ho, M.-C., Huang, T.-W., & Huang, C.-H. (2022). A Soil-Isolated Streptomyces spororaveus Species Produces a High-Molecular-Weight Antibiotic AF1 against Fungi and Gram-Positive Bacteria. Antibiotics, 11(5), 679. https://doi.org/10.3390/antibiotics11050679

